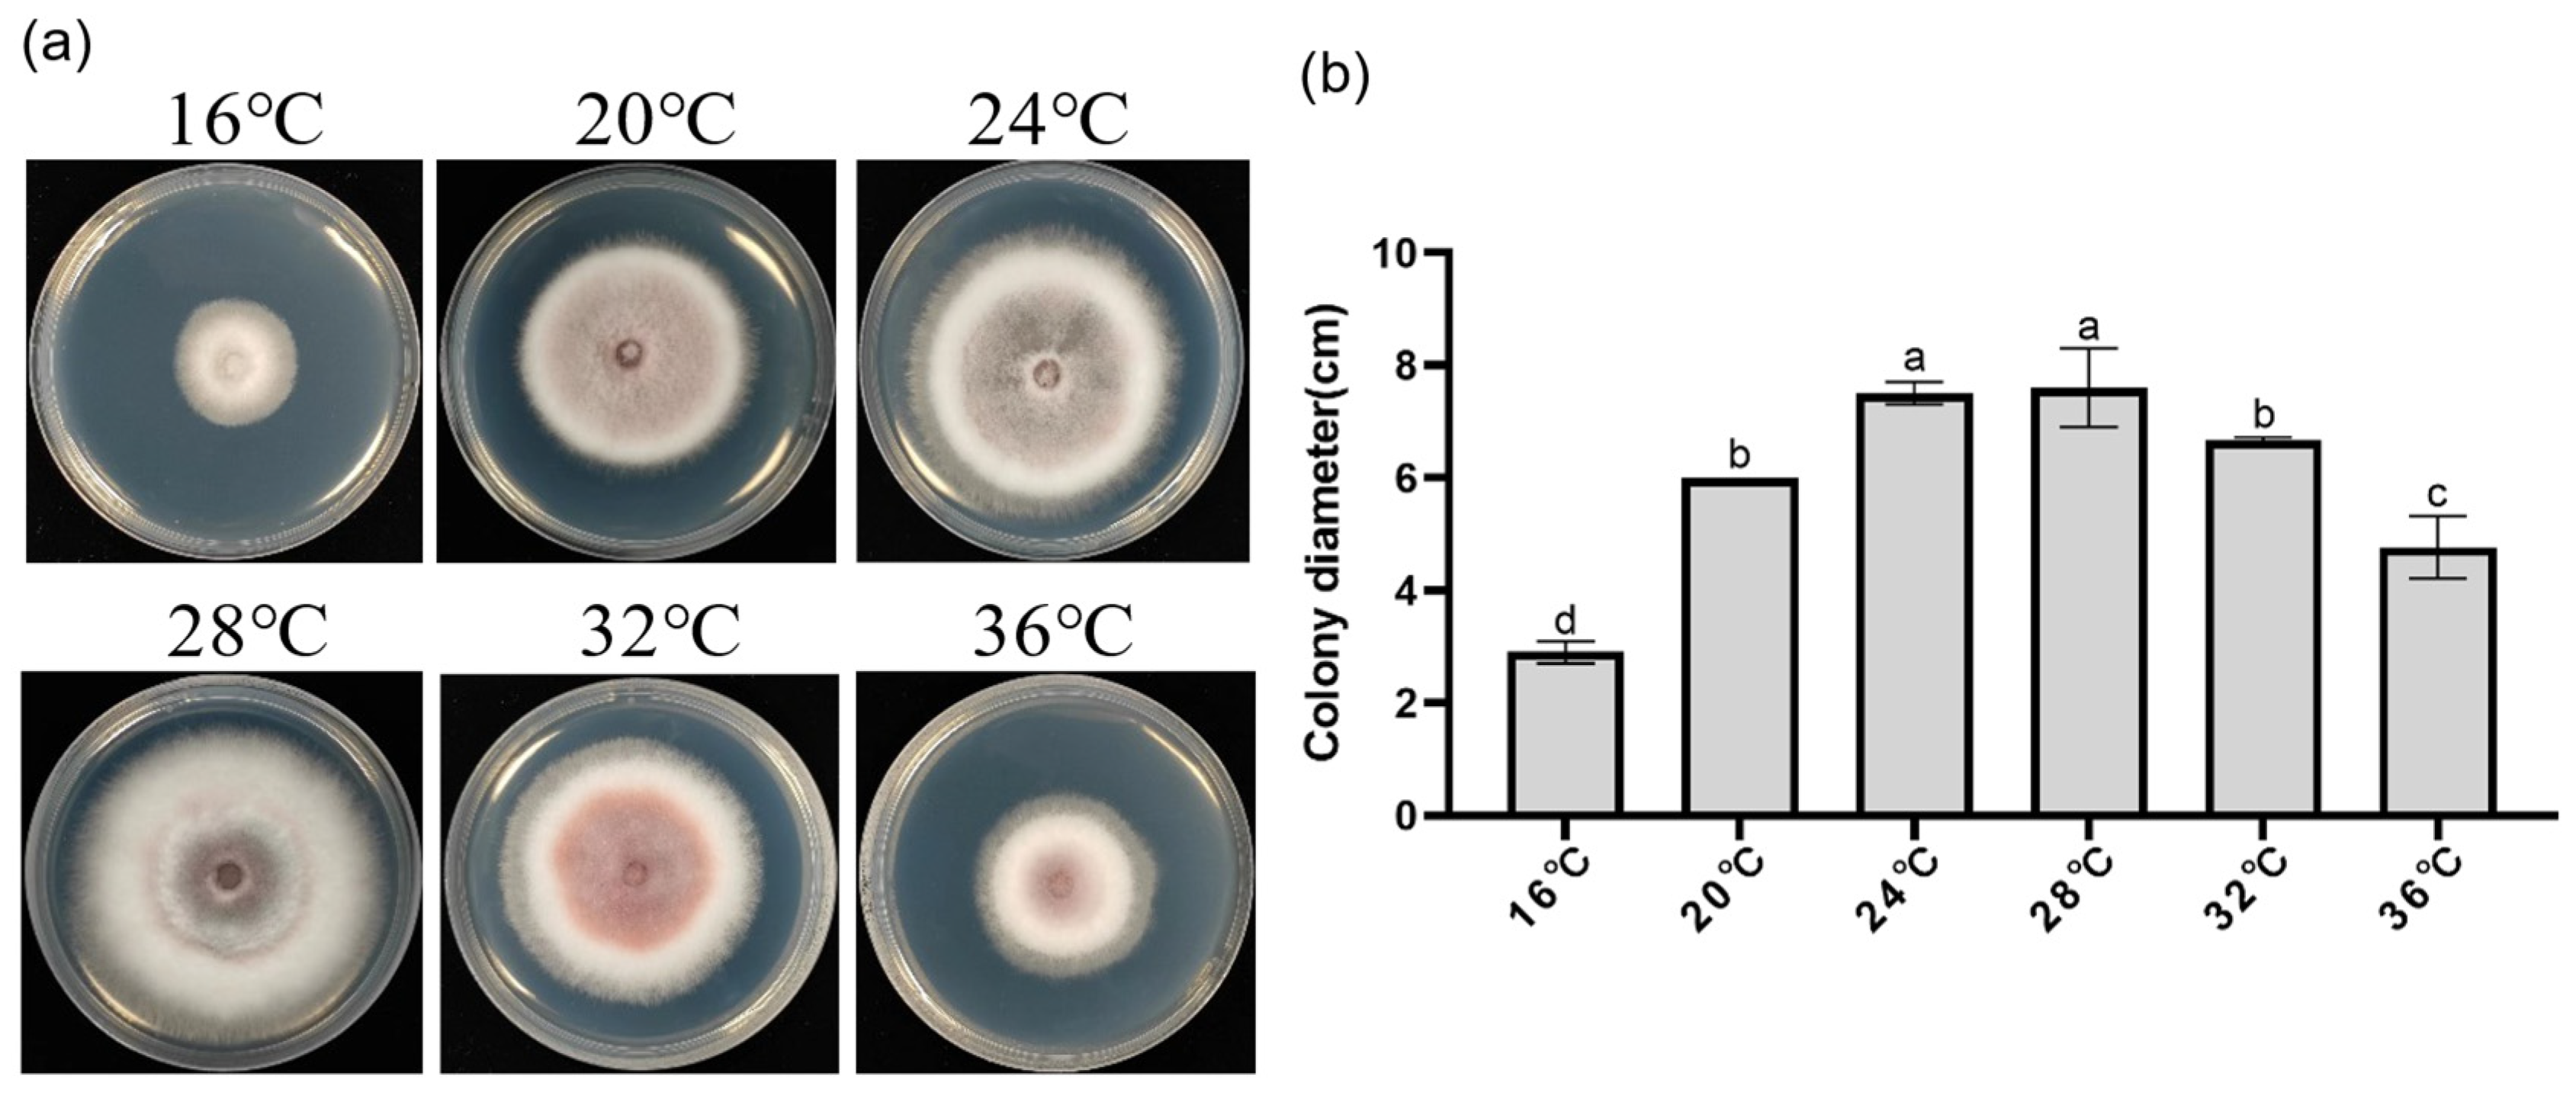
Jof 10 00877 g005
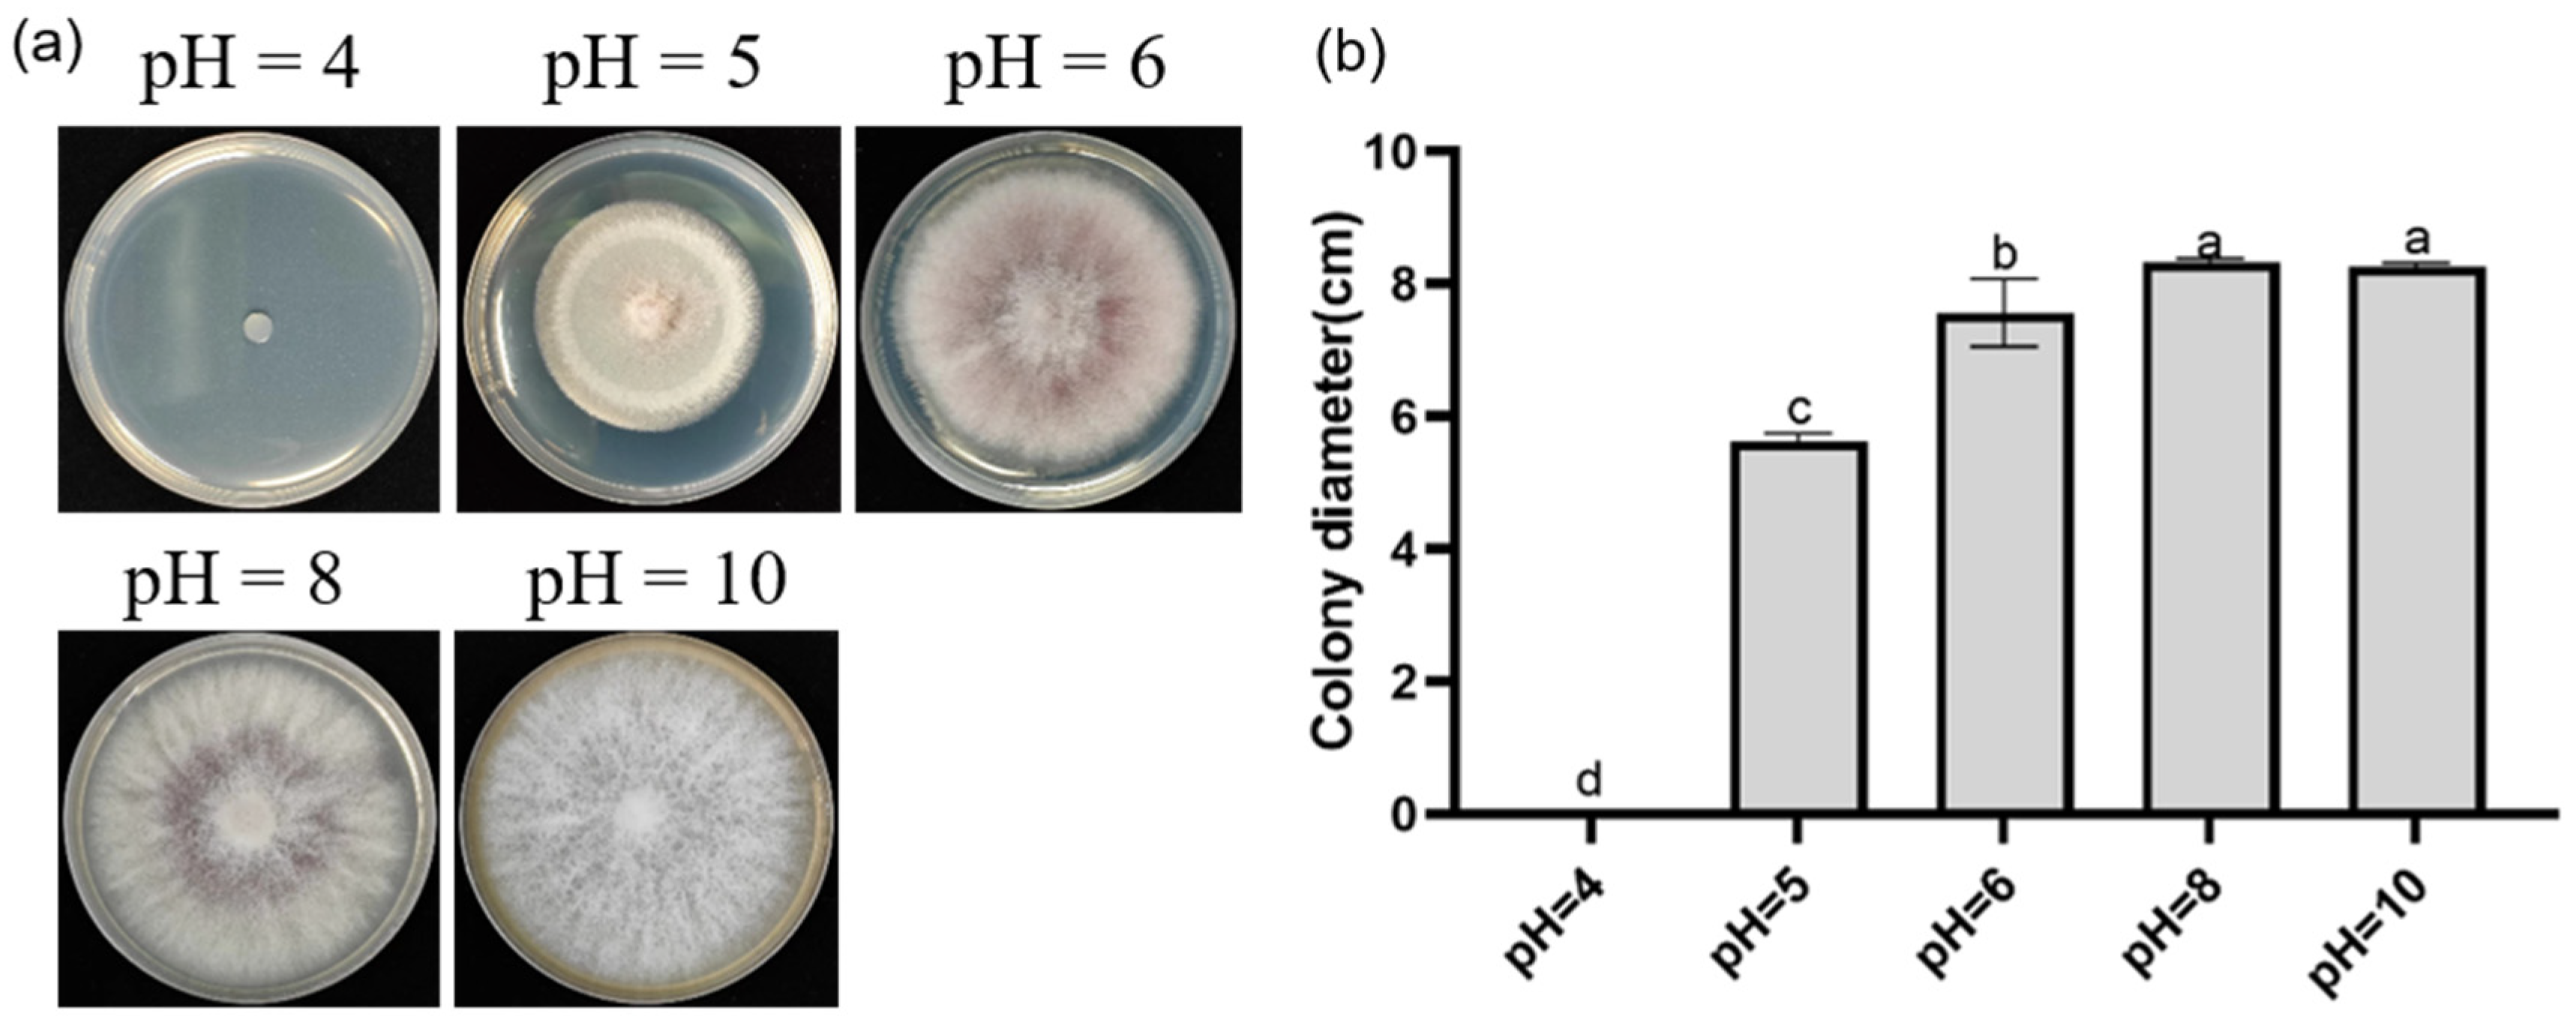
Jof 10 00877 g006

Identification and Characterization of Endophytic Fungus DJE2023 Isolated from Banana (Musa sp. cv. Dajiao) with Potential for Biocontrol of Banana Fusarium Wilt
Abstract
1. Introduction
2. Materials and Methods
2.1. Isolation and Preservation of Endophytic Fungus
2.2. Plant Material and Fungal Inoculation
2.3. Identification of Fungal Isolate DJE2023
2.4. Antagonistic Cultivation
2.5. Biological Characteristics of Endophytic Fungi
2.6. Statistical Analysis
3. Results
3.1. Morphological Characteristics of Endophytic Fungus DJE2023
3.2. Molecular Identification and Phylogenetic Analysis
3.3. Pathogenicity Tests
3.4. Relationship Between Endophytic Fungi and Pathogenic Fungi
3.5. Effects of Carbon Sources, Temperature, and pH on the Growth and Sporulation of Endophytic Fungus DJE2023
4. Discussion
5. Conclusions
Supplementary Materials
Author Contributions
Funding
Institutional Review Board Statement
Informed Consent Statement
Data Availability Statement
Acknowledgments
Conflicts of Interest
Appendix A
| Locus | Primer | Reference | |
|---|---|---|---|
| Name | Sequence (5′-3′) a | ||
| ITS | ITS1 | TCCGTAGGTGAACCTGCGG | [39] |
| ITS4 | TCCTCCGCTTATTGATATGC | ||
| CmdA | 228F | GAGTTCAAGGAGGCCTTCTCCC | [40] |
| 2RD | TGRTCNGCCTCDCGGATCATCTC | ||
| Rpb2 | 5f2 | GGGGWGAYCAGAAGAAGGC | [41] |
| 7cr | CCCATRGCTTGYTTRCCCAT | ||
| Tef1 | EF-1 | ATGGGTAAGGARGACAAGAC | [42] |
| EF-2 | GGARGTACCAGTSATCATGTT | ||
| Species | Isolate | Host | Geographic Area | GenBank Accession Numbers | |||
|---|---|---|---|---|---|---|---|
| ITS | CmdA | Rpb2 | Tef1 | ||||
| F. scirpi | NRRL 36478 | Barley | USA | GQ505743 | GQ505566 | GQ505832 | PQ348098 |
| F. neoscirpi | NRRL 26922 | Wheat | USA | GQ505690 | GQ505513 | GQ505779 | GQ505601 |
| F. brevicaudatum | NRRL 43638 | Triticum aestivum | USA | GQ505754 | GQ505576 | GQ505843 | OP272626 |
| F. arcuatisporum | LC12147 | Maize | Northern America | MK280802 | MK289697 | MK289739 | MK289584 |
| F. cateniforme | CBS 150.25 | Rice | Asian | MH854825 | MN170317 | MN170384 | MN170451 |
| F. equiseti | NRRL 26419 | Hordeum vulgare | South America | GQ505688 | GQ505511 | GQ505777 | PQ549718 |
| F. pernambucanum | NRRL 36548 | Saccharum officinarum | Brazil | GQ505744 | GQ505567 | GQ505833 | GQ505655 |
| F. sulawesiense | LC12169 | Oryza sativa | Sulawesiense | MK280784 | MK289653 | MK289756 | MK289603 |
| F. kotabaruense | InaCCF963 | Saccharum officinarum | Kotabaru | LS479417 | - | LS479859 | LS479445 |
| F. camptoceras | CBS 193.65 | Sorghum bicolor | USA | MH858537 | MN170316 | MN170383 | MN170450 |
| F. concolor | LLC2334 | Sorghum | Africa | - | OP485778 | OP486427 | OP486858 |
| F. concolor | NRRL 13459 | Zea mays | USA | PP336538 | GQ505585 | GQ505852 | GQ505674 |
| F. oxysporum f. sp. cubense | FOC4 | Musa spp. | South East Asia | KF534732 | - | - | JN231165 |
| F. oxysporum f. sp. cubense | FOC1 | Musa spp. | South America | KJ862211 | - | - | KT989071 |
| F. oxysporum | NRRL 22902 | Musa spp. | China | - | - | LT575065 | AF160312 |
| F. oxysporum | Fo47 | Tomato | China | DQ016236 | - | LS479195 | LS479641 |
| F. oxysporum f. sp. lycopersici | Fol4287 | Lycopersicon esculentum | Australia | - | - | LS479200 | LS479646 |
| F. oxysporum f. sp. melonis | Fom001 | Melonis | China | - | - | LS479201 | LS479647 |
| F. graminearum | LC13776 | Secale cereale | USA | MW016612 | - | MW474598 | MW620073 |
| F. oxysporum | DJE2023 | Musa spp. cv. Dajiao | China | PQ603085 | PQ608713 | PQ608711 | PQ608712 |
| Time | Place | Banana Cultivar | Total Plant Population | Number of Infected Plants | Nomber of Plants Surveyed | Incidence of Infected Plants (%) |
|---|---|---|---|---|---|---|
| 15 June 2023 | Machong Town, Dongguan, Guangdong Province | ‘Dajiao’ | 1600 | 0 | 450 | 0.00 |
| 24 August 2023 | 1600 | 0 | 320 | 0.00 | ||
| 13 October 2023 | 1600 | 0 | 823 | 0.00 | ||
| 9 January 2024 | 1600 | 0 | 320 | 0.00 | ||
| 8 March 2024 | 1600 | 0 | 277 | 0.00 |
References
- Ploetz, R.C. Fusarium Wilt of Banana Is Caused by Several Pathogens Referred to as Fusarium oxysporum f. sp. cubense. Phytopathology 2006, 96, 653–656. [Google Scholar] [CrossRef] [PubMed]
- Li, C.; Yang, J.; Li, W.; Sun, J.; Peng, M. Direct Root Penetration and Rhizome Vascular Colonization by Fusarium oxysporum f. sp. cubense are the Key Steps in the Successful Infection of Brazil Cavendish. Plant Dis. 2017, 101, 2073–2078. [Google Scholar] [CrossRef]
- Dale, J.; James, A.; Paul, J.-Y.; Khanna, H.; Smith, M.; Peraza-Echeverria, S.; Garcia-Bastidas, F.; Kema, G.; Waterhouse, P.; Mengersen, K.; et al. Transgenic Cavendish bananas with resistance to Fusarium wilt tropical race 4. Nat. Commun. 2017, 8, 1496. [Google Scholar] [CrossRef] [PubMed]
- Zorrilla-Fontanesi, Y.; Pauwels, L.; Panis, B.; Signorelli, S.; Vanderschuren, H.; Swennen, R. Strategies to Revise Agrosystems and Breeding to Control Fusarium Wilt of Banana. Nat. Food 2020, 1, 599–604. [Google Scholar] [CrossRef] [PubMed]
- Tripathi, J.N.; Ntui, V.O.; Tripathi, L. Precision Genetics Tools for Genetic Improvement of Banana. Plant Genome 2023, 17, e20416. [Google Scholar] [CrossRef]
- Zhao, C.; Li, S.; Du, C.; Gao, H.; Yang, D.; Fu, G.; Cui, H. Establishment of a Protoplasts-Based Transient Expression System in Banana (Musa spp.). Agronomy 2022, 12, 2648. [Google Scholar] [CrossRef]
- Wilson, D. Endophyte: The Evolution of a Term, and Clarification of Its Use and Definition. Oikos 1995, 73, 274–276. [Google Scholar] [CrossRef]
- Akram, S.; Ahmed, A.; He, P.; He, P.; Liu, Y.; Wu, Y.; Munir, S.; He, Y. Uniting the Role of Endophytic Fungi against Plant Pathogens and Their Interaction. J. Fungi 2023, 9, 72. [Google Scholar] [CrossRef] [PubMed]
- Adeleke, B.S.; Ayilara, M.S.; Akinola, S.A.; Babalola, O.O. Biocontrol mechanisms of endophytic fungi. Egypt. J. Biol. Pest Control 2022, 32, 46. [Google Scholar] [CrossRef]
- Ganeshan, K.; Vetrivelkalai, P.; Bhagawati, B.; Gupta, N.; Devrajan, K.; Raveendran, M.; Balachandar, D. Endophytic Fungi as Potential Bio-Control Agents against Root Knot Nematode, Meloidogyne incognita in Banana. Curr. J. Appl. Sci. Technol. 2021, 40, 7–18. [Google Scholar] [CrossRef]
- Nong, Q.; Zhang, W.; Lan, T.; Su, Q.; Chen, Y.; Zhang, Y.; Qin, L.; Xie, L. Screening and Identification of Dark Septate Endophyte Strain L-14 and Its Mechanism of Banana Fusarium Wilt Diease Resistance. Chin. J. Trop. Crops 2017, 38, 559–564. [Google Scholar] [CrossRef]
- Forsyth, L.M.; Smith, L.J.; Aitken, E.A.B. Identification and characterization of non-pathogenic Fusarium oxysporum capable of increasing and decreasing Fusarium wilt severity. Mycol. Res. 2006, 110, 929–935. [Google Scholar] [CrossRef]
- Ma, P.; Li, S.; Huang, H.C.; Tang, W.; Chen, X. Biological Control of Cotton Verticillium Wilt by Avirulent Fusarium spp. Chin. J. Biol. Control 2001, 17, 71–74. [Google Scholar] [CrossRef]
- Yang, P.; Fan, H.; Jin, G.; Guo, Z.; Li, Y.; Liu, S.; Zeng, L. Study on Anitifungal Activity of Banana Rhizosphere and Endophytic Fungi. Southwest China J. Agric. Sci. 2013, 26, 1888–1892. [Google Scholar] [CrossRef]
- Li, D.; Bodjrenou, D.M.; Zhang, S.; Wang, B.; Pan, H.; Yeh, K.-W.; Lai, Z.; Cheng, C. The Endophytic Fungus Piriformospora indica Reprograms Banana to Cold Resistance. Int. J. Mol. Sci. 2021, 22, 4973. [Google Scholar] [CrossRef] [PubMed]
- Khalil, A.M.A.; Hassan, S.E.-D.; Alsharif, S.M.; Eid, A.M.; Ewais, E.E.-D.; Azab, E.; Gobouri, A.A.; Elkelish, A.; Fouda, A. Isolation and Characterization of Fungal Endophytes Isolated from Medicinal Plant Ephedra Pachyclada as Plant Growth-Promoting. Biomolecules 2021, 11, 140. [Google Scholar] [CrossRef] [PubMed]
- Li, M.H.; Yang, B.J.; Leng, Y.Q.; Chao, C.P.; Liu, J.M.; He, Z.F.; Jiang, Z.D.; Zhong, S.B. Molecular characterization of Fusarium oxysporum f. sp. cubense race 1 and 4 isolates from Taiwan and Southern China. Can. J. Plant Pathol. 2011, 33, 168–178. [Google Scholar] [CrossRef]
- Li, M.-H.; Xie, X.-L.; Lin, X.-F.; Shi, J.-X.; Ding, Z.-J.; Ling, J.-F.; Xi, P.-G.; Zhou, J.-N.; Leng, Y.; Zhong, S.; et al. Functional characterization of the gene FoOCH1 encoding a putative α-1,6-mannosyltransferase in Fusarium oxysporum f. sp. cubense. Fungal Genet. Biol. 2014, 65, 1–13. [Google Scholar] [CrossRef]
- Li, M.; Yu, X.; Wang, H.; Zhou, J.; Xi, P.; Jiang, Z. Rapid Detection and Identification of Fusarium oxysporum f. sp. cubense Race 1 and Race 4. Sci. Agric. Sin. 2012, 45, 3971–3979. [Google Scholar] [CrossRef]
- Stamatakis, A. RAxML version 8: A tool for phylogenetic analysis and post-analysis of large phylogenies. Bioinformatics 2014, 30, 1312–1313. [Google Scholar] [CrossRef] [PubMed]
- Cheng, C.; Li, D.; Qi, Q.; Sun, X.; Anue, M.R.; David, B.M.; Zhang, Y.; Hao, X.; Zhang, Z.; Lai, Z. The Root Endophytic Fungus Serendipita Indica Improves Resistance of Banana to Fusarium oxysporum f. sp. cubense Tropical Race 4. Eur. J. Plant Pathol. 2019, 156, 87–100. [Google Scholar] [CrossRef]
- George, D.; Paul, M. IBM SPSS Statistics 26 Step by Step: A Simple Guide and Reference; Routledge: Abingdon, UK, 2019. [Google Scholar]
- Grabka, R.; d’Entremont, T.W.; Adams, S.J.; Walker, A.K.; Tanney, J.B.; Abbasi, P.A.; Ali, S. Fungal Endophytes and Their Role in Agricultural Plant Protection against Pests and Pathogens. Plants 2022, 11, 384. [Google Scholar] [CrossRef] [PubMed]
- Alam, B.; Lǐ, J.; Gě, Q.; Khan, M.A.; Gōng, J.; Mehmood, S.; Yuán, Y.; Gǒng, W. Endophytic Fungi: From Symbiosis to Secondary Metabolite Communications or Vice Versa? Front. Plant Sci. 2021, 12, 791033. [Google Scholar] [CrossRef]
- Goh, C.-H.; Veliz Vallejos, D.F.; Nicotra, A.B.; Mathesius, U. The Impact of Beneficial Plant-Associated Microbes on Plant Phenotypic Plasticity. J. Chem. Ecol. 2013, 39, 826–839. [Google Scholar] [CrossRef]
- Priyashantha, A.K.H.; Karunarathna, S.C.; Lu, L.; Tibpromma, S. Fungal Endophytes: An Alternative Biocontrol Agent against Phytopathogenic Fungi. Encyclopedia 2023, 3, 759–780. [Google Scholar] [CrossRef]
- Zhou, Y.; Yang, L.; Xu, S.; Li, S.; Zeng, L.; Shang, H.; Li, X.; Fan, H.; Zheng, S.-J. Biological Control of the Native Endophytic Fungus Pochonia Chlamydosporia from the Root Nodule of Dolichos Lablab on Fusarium Wilt of Banana TR4. Front. Microbiol. 2024, 15, 1371336. [Google Scholar] [CrossRef] [PubMed]
- Birt, H.W.G.; Pattison, A.B.; Skarshewski, A.; Daniells, J.; Raghavendra, A.; Dennis, P.G. The Core Fungal Microbiome of Banana (Musa spp.). Front. Microbiol. 2023, 14, 1127779. [Google Scholar] [CrossRef]
- Henao, S.Z.; Vásquez, M.C.H.; Hoyos, L.F.P.; Torres, J.D.S.; Hoyos-Carvajal, L.M. Fungal Endophytes in Bananas cv Manzano Affected by Fusarium. Afr. J. Agric. Res. 2019, 14, 430–438. [Google Scholar] [CrossRef]
- Achari, S.R.; Kaur, J.; Dinh, Q.; Mann, R.; Sawbridge, T.; Summerell, B.A.; Edwards, J. Phylogenetic Relationship between Australian Fusarium oxysporum Isolates and Resolving the Species Complex Using the Multispecies Coalescent Model. BMC Genom. 2020, 21, 248. [Google Scholar] [CrossRef] [PubMed]
- Alabouvette, C.; Delabroise, D.; Lemanceau, P.; Couteaudier, Y.; Louvet, J. Utilisation de Souches Non Pathogènes de Fusarium Pour Lutter Contre Les Fusarioses: Situation Actuelle Dans La Pratique1. EPPO Bull. 1987, 17, 665–674. [Google Scholar] [CrossRef]
- Duijff, B.J.; Pouhair, D.; Olivain, C.; Alabouvette, C.; Lemanceau, P. Implication of Systemic Induced Resistance in the Suppression of Fusarium Wilt of Tomato by Pseudomonas fluorescens WCS417r and by Nonpathogenic Fusarium oxysporum Fo47. Eur. J. Plant Pathol. 1998, 104, 903–910. [Google Scholar] [CrossRef]
- Waqar, S.; Bhat, A.A.; Khan, A.A. Endophytic Fungi: Unravelling Plant-Endophyte Interaction and the Multifaceted Role of Fungal Endophytes in Stress Amelioration. Plant Physiol. Biochem. 2024, 206, 108174. [Google Scholar] [CrossRef]
- Chen, C.-Y.; Huang, P.-H.; Yeh, K.-W.; Wang, S.-J. Colonization of Piriformospora Indica Enhances Insect Herbivore Resistance of Rice Plants through Jasmonic Acid- and Antioxidant-Mediated Defense Mechanisms. J. Plant Interact. 2021, 17, 9–18. [Google Scholar] [CrossRef]
- Li, M.; Xie, L.; Wang, M.; Lin, Y.; Zhong, J.; Zhang, Y.; Zeng, J.; Kong, G.; Xi, P.; Li, H.; et al. FoQDE2-Dependent MilRNA Promotes Fusarium oxysporum f. sp. cubense Virulence by Silencing a Glycosyl Hydrolase Coding Gene Expression. PLoS Pathog. 2022, 18, e1010157. [Google Scholar] [CrossRef]
- Xie, L.; Bi, Y.; He, C.; Situ, J.; Wang, M.; Kong, G.; Xi, P.; Jiang, Z.; Li, M. Unveiling MicroRNA-like Small RNAs Implicated in the Initial Infection of Fusarium oxysporum f. sp. cubense through Small RNA Sequencing. Mycology 2024, 1–16. [Google Scholar] [CrossRef]
- He, J.; Zhong, J.; Jin, L.; Long, Y.; Situ, J.; He, C.; Kong, G.; Jiang, Z.; Li, M. A Virulent MilRNA Inhibits Host Immunity by Silencing a Host Receptor-like Kinase MaLYK3 and Facilitates Infection by Fusarium Oxysporum f. sp. cubense. Mol. Plant. Pathol. 2024, 25, e70016. [Google Scholar] [CrossRef]
- Dalakouras, A.; Katsaouni, A.; Avramidou, M.; Dadami, E.; Tsiouri, O.; Vasileiadis, S.; Makris, A.; Georgopoulou, M.E.; Papadopoulou, K.K. A beneficial fungal root endophyte triggers systemic RNA silencing and DNA methylation of a host reporter gene. RNA Biol. 2023, 20, 20–30. [Google Scholar] [CrossRef] [PubMed]
- White, T.J.; Bruns, T.; Lee, S.; Taylor, J. Amplification and Direct Sequencing of Fungal Ribosomal RNA Genes for Phylogenetics; Elsevier: Amsterdam, The Netherlands, 1990; pp. 315–322. [Google Scholar]
- Quaedvlieg, W.; Kema, G.H.J.; Groenewald, J.Z.; Verkley, G.J.M.; Seifbarghi, S.; Razavi, M.; Gohari, A.M.; Mehrabi, R.; Crous, P.W. Zymoseptoria gen. nov.: A new genus to accommodate Septoria-like species occurring on graminicolous hosts. Pers. Int. Mycol. J. 2011, 26, 57–69. [Google Scholar] [CrossRef]
- O’Donnell, K.; Sutton, D.A.; Rinaldi, M.G.; Sarver, B.A.J.; Balajee, S.A.; Schroers, H.-J.; Summerbell, R.C.; Robert, V.A.R.G.; Crous, P.W.; Zhang, N.; et al. Internet-Accessible DNA Sequence Database for Identifying Fusaria from Human and Animal Infections. J. Clin. Microbiol. 2010, 48, 3708–3718. [Google Scholar] [CrossRef] [PubMed]
- O’Donnell, K.; Kistler, H.C.; Cigelnik, E.; Ploetz, R.C. Multiple Evolutionary Origins of the Fungus Causing Panama Disease of Banana: Concordant Evidence from Nuclear and Mitochondrial Gene Genealogies. Proc. Natl. Acad. Sci. USA 1998, 95, 2044–2049. [Google Scholar] [CrossRef] [PubMed]

Disclaimer/Publisher’s Note: The statements, opinions and data contained in all publications are solely those of the individual author(s) and contributor(s) and not of MDPI and/or the editor(s). MDPI and/or the editor(s) disclaim responsibility for any injury to people or property resulting from any ideas, methods, instructions or products referred to in the content. |
© 2024 by the authors. Licensee MDPI, Basel, Switzerland. This article is an open access article distributed under the terms and conditions of the Creative Commons Attribution (CC BY) license (https://creativecommons.org/licenses/by/4.0/).
Share and Cite
Jin, L.; Huang, R.; Zhang, J.; Li, Z.; Li, R.; Li, Y.; Kong, G.; Xi, P.; Jiang, Z.; Li, M. Identification and Characterization of Endophytic Fungus DJE2023 Isolated from Banana (Musa sp. cv. Dajiao) with Potential for Biocontrol of Banana Fusarium Wilt. J. Fungi 2024, 10, 877. https://doi.org/10.3390/jof10120877
Jin L, Huang R, Zhang J, Li Z, Li R, Li Y, Kong G, Xi P, Jiang Z, Li M. Identification and Characterization of Endophytic Fungus DJE2023 Isolated from Banana (Musa sp. cv. Dajiao) with Potential for Biocontrol of Banana Fusarium Wilt. Journal of Fungi. 2024; 10(12):877. https://doi.org/10.3390/jof10120877
Chicago/Turabian StyleJin, Longqi, Rong Huang, Jia Zhang, Zifeng Li, Ruicheng Li, Yunfeng Li, Guanghui Kong, Pinggen Xi, Zide Jiang, and Minhui Li. 2024. "Identification and Characterization of Endophytic Fungus DJE2023 Isolated from Banana (Musa sp. cv. Dajiao) with Potential for Biocontrol of Banana Fusarium Wilt" Journal of Fungi 10, no. 12: 877. https://doi.org/10.3390/jof10120877
APA StyleJin, L., Huang, R., Zhang, J., Li, Z., Li, R., Li, Y., Kong, G., Xi, P., Jiang, Z., & Li, M. (2024). Identification and Characterization of Endophytic Fungus DJE2023 Isolated from Banana (Musa sp. cv. Dajiao) with Potential for Biocontrol of Banana Fusarium Wilt. Journal of Fungi, 10(12), 877. https://doi.org/10.3390/jof10120877

